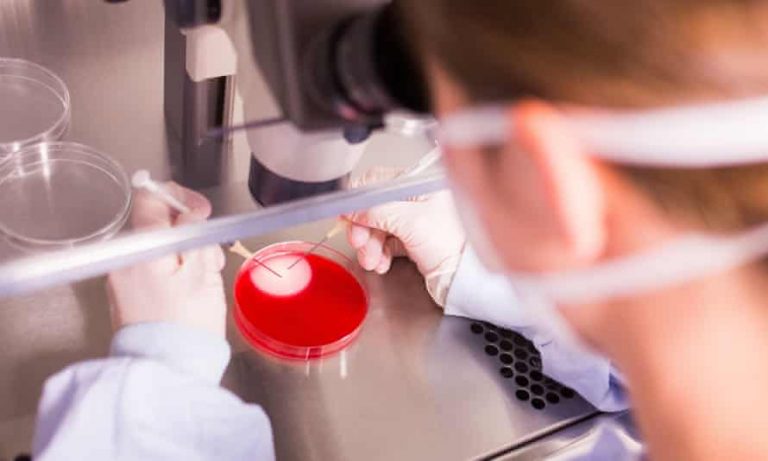

Aprena Manrose buat rawatan kesuburan, belajar berhijab
24 Jun 2021, 5:26 pm

Taiwan miliki rakyat paling tidak subur di dunia
22 April 2021, 12:00 pm
Trend wanita bekukan sel telur ketika musim Covid-19
29 Mac 2021, 10:35 pm





![[VIDEO] Lipatlah bumi ini Ina!](https://www.kosmo.com.my/wp-content/uploads/2024/11/WhatsApp-Image-2024-11-21-at-20.04.05-120x86.jpeg)

